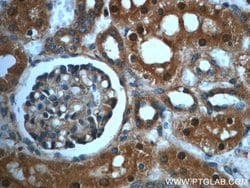
PAWR Rabbit anti-Human, Mouse, Rat, Polyclonal, Proteintech:Antibodies:Primary

missing translation for 'onlineSavingsMsg'
Learn More
Learn More
PAWR Rabbit anti-Human, Mouse, Rat, Polyclonal, Proteintech
Rabbit Polyclonal Antibody
€ 145.00 - € 410.00
Specifications
| Antigen | PAWR |
|---|---|
| Concentration | 0.4 mg/mL |
| Applications | Immunohistochemistry (Paraffin), Western Blot |
| Classification | Polyclonal |
| Conjugate | Unconjugated |
| Product Code | Brand | Quantity | Price | Quantity & Availability | |||||
|---|---|---|---|---|---|---|---|---|---|
| Product Code | Marke | Quantity | Preis | Menge & Verfügbarkeit | |||||
|
16870265
|
Proteintech
20688-1-AP-20UL |
20 μL |
€ 145.00
20µL |
Please sign in to purchase this item. Need a web account? Register with us today! | |||||
|
16860265
|
Proteintech
20688-1-AP-150UL |
150 μL |
€ 410.00
150µL |
Please sign in to purchase this item. Need a web account? Register with us today! | |||||
Beschreibung
The antibody is specific to PAWR.
This gene encodes a tumor suppressor protein that selectively induces apoptosis in cancer cells through intracellular and extracellular mechanisms. The intracellular mechanism involves the inhibition of pro-survival pathways and the activation of Fas-mediated apoptosis, while the extracellular mechanism involves the binding of a secreted form of this protein to glucose regulated protein 78 (GRP78) on the cell surface, which leads to activation of the extrinsic apoptotic pathway. This gene is located on the unstable human chromosomal 12q21 region and is often deleted or mutated different tumors. The encoded protein also plays an important role in the progression of age-related diseases.Spezifikation
| PAWR | |
| Immunohistochemistry (Paraffin), Western Blot | |
| Unconjugated | |
| Rabbit | |
| Rat, Human, Mouse | |
| Q62627, Q925B0, Q96IZ0 | |
| 114774, 5074, 64513 | |
| Peptide | |
| Primary | |
| -20°C | |
| PAWR |
| 0.4 mg/mL | |
| Polyclonal | |
| Liquid | |
| RUO | |
| PBS with 50% glycerol and 0.02% sodium azide; pH 7.3 | |
| Par 4, PAR4, PAWR, Prostate apoptosis response 4 protein | |
| Pawr | |
| IgG | |
| Antigen Affinity Chromatography | |
| Antibody |
Haben Sie Verbesserungsvorschläge?Übermitteln Sie eine inhaltliche Korrektur
Berichtigung von Produktinhalten
Bitte geben Sie uns Ihr Feedback zu den Produktinhalten, indem Sie das folgende Formular ausfüllen.
Name des Produkts